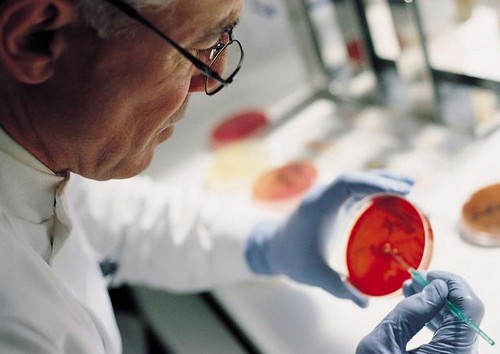

A Billion Wicked Thoughts è stata annunciata come la più grande ricerca sui gusti sessuali della popolazione americana dopo quella effettuata da Kinsey. Gli autori del volume Ogi Ogas e Sai Gaddam hanno dichiarato che il progetto è nato per capire quanto Internet ha influito sulla sessualità delle persone.
A Billion Wicked Thoughts è stata annunciata come la più grande ricerca sui gusti sessuali della popolazione americana dopo quella effettuata da Kinsey. Gli autori del volume Ogi Ogas e Sai Gaddam hanno dichiarato che il progetto è nato per capire quanto Internet ha influito sulla sessualità delle persone.
Ogas e Gaddam hanno scoperto che gli uomini eterosessuali godono di una impensabile varietà di fantasie sessuali. Tra le fantasie sessuali che i maschi etero non ammetterebbero neanche sotto tortura ci sono i transessuali e le donne anziane.





 I ricercatori National Institute of Biological Sciences di Pechino hanno dimostrato che alcune sostanze chimiche posso modificare l’orientamento sessuale dei topi maschi.
I ricercatori National Institute of Biological Sciences di Pechino hanno dimostrato che alcune sostanze chimiche posso modificare l’orientamento sessuale dei topi maschi.